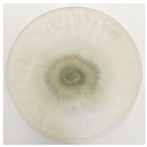
Jmse 12 01629 i003
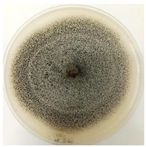
Jmse 12 01629 i009

Abstract
The accumulation of microplastics (MPs) in the environment has been a bottleneck for scientific society. Several approaches have been described as possibilities for reducing MPs in aquatic and terrestrial ecosystems; however, most of them are not environmentally friendly. Filamentous fungi (Ff) cells are currently considered a promising solution as a treatment for MPs. Therefore, the present study reports the potential ability of Ff isolated from mangrove sediments to biodegrade low-density polyethylene MPs (LDPEMPs). Six Ff strains were grown in batch cultures for 28 days, and one of them, Aspergillus sp. (AQ3A), showed the most prominent profile to biodegrade polymeric compounds. After morphological and molecular analysis, all strains were identified as belonging to the genera Aspergillus (MQ1C, AQ2A and AQ3A), Penicillium (MQ1A), and Trichoderma (MQ1B and MQ2A). The strain Aspergillus sp. (AQ3A) showed the most promising results with a LDPEMPs reduction rate of 47% and biomass formation of 0.0890 g·mL−1. Complementary studies with Aspergillus sp. (AQ3A) using Fourier-transform infrared spectroscopy (FTIR) highlighted changes in the molecular structure of LDPEMPs. These results indicate that Ff can contribute to the biodegradation of LDPEMPs. However, other parameters, mainly associated with the enzymes that are involved in this biodegradation process, need to be explored.
1. Introduction
Plastic pollution is among the worst environmental disasters caused by humans. According to their size, these polymers are classified as megaplastics (>1 m), macroplastics (1 m to 25 mm), mesoplastics (25 to 5 mm), microplastics (5 mm to 1 μm), and nanoplastics (<1 μm). Microplastics (MPs) are generated during the manufacturing of products on an industrial scale (primary MPs, usually as pellets and granules) or by the fragmentation of plastic materials (secondary MPs, usually fragments, fibers, films, and foams) [1]. According to Liu et al. [2], by the year 2060, MPs will correspond to 13.2% of plastic pollutants in the world. MPs waste is long-lasting and accumulates rapidly in terrestrial and aquatic environments. MPs residues are long-lasting and accumulate rapidly in terrestrial and aquatic environments. Most of the MPs found in terrestrial environments are polyethylene (PE), polypropylene (PP), polyethylene terephthalate (PET), and polyvinyl chloride (PVC). However, in aquatic environments (ocean beds, river sediments, and beaches), in addition to PE and PP, polystyrene (PS) and expandable polystyrene (EPS) are more frequently detected [3].
Although MPs are mainly produced, used, and disposed of in the terrestrial environment [4], aquatic ecosystems are more vulnerable. According to Madhumitha et al. [5], rivers, lakes, estuaries, and coastal and marine sediments serve as reservoirs of MPs. Currently, rivers are considered the main focus of MPs concentration due to their proximity to sources of plastic pollution, such as cities and industries [6]. MPs can be ingested by aquatic organisms belonging to different trophic levels, and their impact expands through both the aquatic and terrestrial food chains [7]. Ziajahromi et al. [8] observed a negative impact of polyethylene microplastics (PEMPs) on the survival, growth, and emergence of dipterans after exposure to different material sizes. Détréee and Gallardo-Escárte [9], as well as Solomando et al. [10], identified damage to homeostasis, stress-related processes, and the immune system in mussels exposed to PEMPs. Moreover, they observed the induction of antioxidant enzymes, hepatic and plasma oxidative damage, and elevations in plasma lysozyme levels and myeloperoxidase activity in plasma. Oxidative stress induced in human brain cells exposed to PEMPs for 24 h was also reported by Schirinzi et al. [11].
Physical, chemical, or biological methods can be used in the MP degradation process. However, in recent years, biological degradation, also called biodegradation, has been receiving special attention since it is an ecological approach and covers the sustainable development goals 12 (responsible consumption and production), 14 (water life), and 15 (terrestrial life) of the 2030 Agenda for Sustainable Development proposed by the United Nations. The biodegradation method applies microorganisms as cellular biocatalysts [12,13]. Microorganisms, as described by Miri et al. [14] and Thakur et al. [15], degrade the long chains of MPs into oligomers, dimers, and monomers using extracellular enzymes. This process provides a carbon source for their growth and metabolism. Additionally, in an aerobic environment, they release water (H2O) and carbon dioxide (CO2), while under anaerobic conditions, the mineralization process results in the production of methane (CH4) and CO2 [15,16,17]. Recently, Kumar et al. [18] highlighted that the microbial enzymes involved in the biodegradation of MPs can be categorized into two groups: (a) surface-modifying enzymes (These include lipases, cutinases, proteases, and esterases. While they do not directly break complex polymer bonds, they facilitate the condition for active colonization by degrading organisms. Also, they increase the hydrophilicity of MPs.), and (b) depolymerizing enzymes (These break down the polymer chains, producing monomeric residues for subsequent microbial metabolism. Examples include hydrolases, laccases, oxidases, amidases, and peroxidases).
Filamentous fungi (Ff) stand out as promising microorganisms due to their recognized ability to mineralize recalcitrant compounds and xenobiotics. According to Sánchez [19] and Bacha et al. [12], Ff mycelia can penetrate hydrophobic surfaces, expanding the action of several extra- and intracellular enzymes, presenting activities superior to those of bacteria. Among fungal phyla, Ascomycota, Basidiomycota, and Mucoromycota are the most promising for MPs degradation, with the genera Penicillium and Aspergillus being the most referenced [20]. Zhang et al. [21] reported that the fungus Aspergillus flavus PEDX3 effectively degraded high- and low-density PEMPs after 28 days of incubation. The results indicated that two laccase-like multicopper oxidase enzymes reached a peak of activity on the 21st day of incubation, and Fourier-transform infrared spectroscopy (FTIR) analysis revealed new functional groups (hydroxyl (3500–3100 cm−1), ether (1113 cm−1), and carbonyl (1647–1716 cm−1)), indicating the bio-oxidation effect by A. flavus PEDX3. Paço et al. [22] described the efficiency of the marine fungus Zalerion maritimum in degrading PEMPs. The authors observed an inversely proportional relationship between Z. maritimum biomass formation and PEMPs mass reduction, resulting in a 43% removal of polymeric material. In fact, Ff produce exoenzymes that create intermediate compounds with modified properties, increasing cellular assimilation. These compounds are then used by the cells as carbon sources, being decomposed into H2O and CO2 or CH4 to complete the mineralization process [23]. Thus, selecting new fungal strains capable of biodegrading MPs and optimizing the biodegradation processes of these polymeric materials are essential steps for their effective large-scale application. Moreover, bioprospecting Ff in mangroves is crucial due to their significant microbial diversity and the potential discovery of novel species with unique enzymatic capabilities [24], which can be harnessed for the biodegradation of microplastics, thereby contributing to the mitigation of plastic pollution in these threatened ecosystems. Due to the lack of comprehensive studies on the performance of fungal MPs degradation, this study presents a screening to identify mangrove Ff with the ability to degrade low-density polyethylene (LDPE).
2. Materials and Methods
2.1. Low-Density Polyethylene Microplastics Morphological Characterization and Sterilization
The low-density polyethylene (LDPE) MPs (LDPEMPs) were obtained from local commerce in São Vicente, Brazil. Twenty-five grams of LDPEMPs were added to a mechanical shaker equipped with sieves of different mesh sizes (500, 355, 250, 180, 125, and 63 µm). They were separated by size and, with the aid of a stereoscope, categorized by morphological type [25]. The LDPEMPs were then submerged in 70% alcohol for 15 min and subsequently irradiated under ultraviolet (UV) light for 30 min.
2.2. Sample Collection and Isolation
Surface mangrove sediment samples were collected at six sampling sites (one sample per site) at a depth of 30 cm (Figure 1): MQ1 (24°26′2.30″ S, 47°5′57.9″ O), MQ2 (24°26′1.9″ S, 47°5′57.7″ O), MQ3 (24°26′1.1″ S, 47°5′57.6″ O), AQ1 (24°25′58.9″ S, 47°5′56.5″ O), AQ2 (24°25′58.2″ S, 47°5′57.6″ O), and AQ3 (24°25′58″ S, 47°5′56.8″ O). These collections were made at the Ecological Station of Juréia-Itatins, Peruíbe, Brazil, in February 2018. The sediment samples were aseptically taken into 50 mL sterile Falcon tubes and stored at 4 °C. A fungal isolation protocol was followed as previously described by [26,27]. One gram of each sediment sample was diluted in 9 mL of sterile minimal medium (MM) containing (grams per liter of distilled water): NaNO3, 2.0; KH2PO4, 0.7; K2HPO4, 0.3; KCl, 0.5; MgSO4·7H2O, 0.5; FeSO4·7H2O, 0.1; and, incubated at 30 °C, 50 rpm, for 1 h. A volume of 100 µL of the inoculum, obtained from serial dilution technique (until 10−6), was aseptically incorporated into Petri plates containing solid MM (SMM, with incorporation of agar 15 g/L) and potato dextrose agar (PDA, Merck, Millipore, Burlington, MA, USA), and then incubated at 30 °C for 7 days. Axenic cultures were obtained after approximately 6 weeks. Strains were kept as conidial suspensions in 20% glycerol at −80 °C, and in PDA plugs suspended in sterile water at room temperature. Seven days before the assays, fungi were activated on PDA at 30 °C.
Figure 1.
Location of the sampling site at the Ecological Station of Juréia-Itatins, Peruíbe, Brazil.
2.3. Morphological Identification
The macroscopy and microscopy analysis of fungal morphology was assessed by previously defined protocols [28,29]. The fungal isolates were inoculated into PDA and incubated at 30 °C for 7 days. Macroscopic features such as conidial color, reverse color, and texture of colonies were observed and noted. Microscopic features (conidiophores, stipes, and ornamentation) were analyzed using an optical microscope. Briefly, a loopful culture was picked up with the help of a sterile inoculation loop, and semi-permanent slides were prepared using lactophenol cotton blue. The slides were gently heated in a spirit lamp to release any air bubbles trapped between the coverslip and the slide. The excess stain was removed by using tissue paper and the cover glass was sealed with nail polish.
2.4. Molecular Identification
Genomic DNA extraction of fungal isolates was performed from the biomass of each strain. Thus, the fungal strains were cultivated in a 250 mL Erlenmeyer flask containing 50 mL of mycobacterial methylglucose liposaccharide medium (10 g·L−1 glucose, 3 g·L−1 malt extract, 3 g·L−1 yeast extract, and 5 g·L−1 bacteriological peptone), incubated at 30 °C under agitation at 150 rpm, for 5 days. Amplification of the internal transcribed spacer (ITS) region of the ribosomal nuclear DNA (700–1400 bp) was performed using the primer pair ITS1F/ITS4 (CTTGGTCATTTAGAGGAAGTAA/TCCTCCGCTTATTGATATGC), except for the samples MQ1B and MQ2A, which used the primer pair ITS5/ITS4 (GGAAGTAAAAGTCGTAACAAGG/TCCTCCGCTTATTGATATGC) [30,31] due to amplification issues with the ITS1F/ITS4 pair. The polymerase chain reaction (PCR) was performed in a thermal cycler with the following mixture: 0.2 μL of Taq DNA Polymerase GE Healthcare™, 0.5 μL of dNTP MIX (Promega Corporation™, Madison, WI, USA) 100 parts mol·μL−1 of each primer, 1 μL of DNA template in a solution of 2.5 μL of 10X PCR Buffer (GE Healthcare™, Chicago, IL, USA), and 18.8 μL of MilliQ water, in a final volume of 25 μL. The amplification program comprised one cycle at 95 °C for 4 min, 35 cycles at 94 °C for 30 s, 52 °C for 30 s, and 72 °C for 1 min, with a final extension cycle at 72 °C for 8 min. The amplified fragments were checked by electrophoresis in 1% agarose gel. The PCR products were purified with the PureLink™ PCR Purification KIT (Invitrogen™, Carlsbad, CA, USA) and sequenced at the Center for Human Genome and Stem Cell Studies of the Institute of Biosciences of the São Paulo University, Brazil.
The forward and reverse sequences were examined and aligned using the BioEdit 7.0.9 software [32] to obtain consensus sequences for subsequent analyses. The ITS sequences obtained were deposited in the Genbank® database [33] (accession numbers indicated in Table 1) and compared with those available at the same database of the National Center for Biotechnology Information (NCBI) using the Basic Local Alignment Search Tool (BLAST) software (version + 2.16.0) [34]. Sequences from type and reference materials of species previously recorded in Brazil were selected (Table 1), considering the genera identified with the highest identity (%) in the BLAST analysis. This sequence and sequences of species from other orders of the phylum Ascomycota (Diaporthales and Glomerellales) used as outgroups were downloaded for subsequent analyses.
Table 1.
Internal transcribed spacers (ITS) sequences of representative taxa were included in the phylogenetic analysis and their Genbank accession numbers. * Sequences obtained in this study.
The sequences were organized into a matrix and subjected to alignment using the ClustalW application [35] implemented in BioEdit software (version 7.2.5) [30]. The final aligned matrix with an extension of 577 bp was subjected to analysis to select the best-fit model of nucleotide substitution using the ModelTest application in the online platform FindModel [36]. Phylogenetic analysis was performed in MrBayes 3.2.7a software [37] using the general time reversible model with gamma distribution (GTR+G) previously selected. Two independent runs (nruns = 2) with four Metropoli Coupled Markov chains (nchains = 4) [38] were performed for 1 × 106 generations, sampling one tree every 1000 trees and discarding the first 25% of trees as burn-in after reaching convergence (standard deviation = 0.01). The posterior probabilities were evaluated from the 50% majority rule consensus tree and the final tree was visualized and edited in FigTree 1.4.4 [39].
2.5. Microorganisms and Culture Conditions
Six different filamentous fungi strains (coded as MQ1A, MQ1B, MQ1C, MQ2A, AQ2A, and AQ3A) were selected to grow in batch cultures to assess their abilities to biodegrade LDPEMPs. From the stock cultures grown in PDA, 1 culture disk (6 mm diameter) of each strain was individually transferred to a Petri dish containing SMM [26,27]. All Petri dishes were incubated for 7 days at 30 °C. Then, five plugs of 6 mm from these cultures were incorporated into 250 mL Erlenmeyer flasks containing 50 mL of MM [22] and 0.05 g LDPEMPs. Cultures were incubated in an orbital shaker (NT712, Novatecnica, Piracicaba, Brazil) at 30 °C and 150 rpm for 28 days. In order to compare the variation in biomass formation and biodegradation of LDPEMPs, controls were performed under identical conditions in the absence of inoculum or LDPEMPs. Samples for analysis were collected in the 7th, 14th, 21st, and 28th days of incubation. All samples were measured in duplicate.
2.5.1. Biomass Concentration
The fungal biomass was initially separated from the LDPEMPs using a 500 μm mesh sieve. Biomass formation was determined by dry cell weight per volume (g·L−1). The biomass was obtained by filtration of the fermentation broth, then washed with distilled water, and finally dried at 105 °C for 4 h.
2.5.2. Low-Density Polyethylene Microplastics Biodegradation
LDPEMPs attached to fungal biomass were exposed to 30% hydrogen peroxide [40,41]. Subsequently, the LDPEMPs were sieved using mesh sizes of 250, 180, 125 and 63 μm. After this treatment, the LDPEMPs were washed with distilled water, followed by vacuum filtration with qualitative filter paper (45 μm), and dried at 30 °C for 24 h.
2.5.3. Fourier-Transform Infrared Spectroscopy
The LDPEMPs were analyzed by Fourier-transform infrared spectroscopy (FTIR) using the equipment Nicolet 6700 (Thermo Fisher Scientific, Waltham, MA, USA), operated from 450 to 4000 cm−1.
2.6. Laccase Activity Assay
Laccase activity was determined by the changes in the absorbance at 420 nm, related to the rate of oxidation of 1.5 mM 2,2′-azinobis-[3-ethyltiazoline-6-sulfonate] (ABTS) in a 100 mM sodium acetate buffer (pH 4.0) [42]. The assay reaction mixture was measured in a cuvette using a spectrophotometer (600S, FEMTO, Indústria e Comércio de Instrumentos, São Paulo, Brazil). One unit of enzyme activity was defined as the amount of enzyme required to oxidize 1 µmol of ABTS per minute (ε420 = 3.6 × 104 M−1·cm−1) under the chosen experimental conditions.
3. Results
3.1. LDPEMPs Size and Morphology
The sizes of the LDPEMPs ranged from 500 to <63 μm. The most frequently occurring granulometric classes were 250 μm (29%) and 355 μm (23%), followed by 125 μm (20%), 180 μm (19%), 63 μm (7%), with both 500 μm and <63 μm each accounting for only 1%. According to Figure 2, the polymer samples were mainly composed of microspheres; however, microfragments and microfibres were also found.
Figure 2.
Morphology of low density polyethylene microplastics: (A) microfiber, (B) microfragments, and (C) microsphere.
3.2. Morphological and Molecular Identification
Fifty-eight fungal colonies from mangrove sediments were isolated in PDA medium. Six of these isolates were evaluated for their ability to degrade LDPEMPs. Microscopic analyses allowed the identification of the genera Aspergillus, Penicillium and Trichoderma. As shown in Table 2, the microorganisms were characterized macroscopically and microscopically. The strains of the genus Aspergillus (MQ1C, AQ2A and AQ3A) presented septate hyphae, biseriate conidiophores containing two palisades of compacted cells of metulae and phialides, as well as colonies with a velvety surface and high sporulation. Penicillium sp. (MQ1A) exhibited slow growth with a white mycelium, converting into a colony with a bluish-green velvety surface. The strains of Trichoderma aff. pseudokoningii (MQ1B and MQ2A), were characterized by initially exhibiting a white mycelium and rapid growth, becoming cottony and compact with green pigmentation. The single strain of the genus Penicillium (MQ1A) showed velvety white features followed by a bluish-green coloration.
Table 2.
Macroscopic and microscopic fungal colonies characteristics on potato dextrose agar (PDA). Petri dishes in the “macroscopic appearance” column had a diameter of 90 mm, and “microscopic appearance” images were obtained using a 40x objective.
The fungal isolates belong to the phylum Ascomycota and are distributed in three genera: Aspergillus (AQ2A, AQ3A, MQ1C), Penicillium (MQ1A) and Trichoderma (MQ1B, MQ2A). In the tree (Figure 3), they were grouped into two monophyletic groups representing the genera Penicillium and Trichoderma. However, the Aspergillus species included in the analysis do not appear as a monophyletic group because they resulted in a polytomy with the isolate MQ1C, the species A. ventii, and the Penicillium clade. These two genera belong to the same order Eurotiales, and the results suggest that the ITS marker or the inclusion of a few species is not sufficient to obtain monophyletic groupings of these genera or to identify the isolates to the species level. Isolates AQ2A and AQ3A were recognized as belonging to the genus Aspergillus; however, they did not group with any of the species included in the analysis, which may indicate that they belong to other species of the genus not represented in Genbank® or to species not yet recorded in Brazil. The results of the analysis suggest that isolate MQ1A represents the species Penicillum aff. chrysogenum, and isolates MQ1B and MQ2A represent the species Trichoderma aff. pseudokoningii with posterior probabilities of 0.71 and 0.99, respectively.
Figure 3.
Bayesian tree of internal transcribed spacers (ITS) sequences, obtained from fungal isolates (AQ2A, AQ3A, MQ1A, MQ1B, MQ1C, and MQ2A) and related species previously recorded in Brazil. Numbers above the branches indicate posterior probabilities, and the bar indicates the number of nucleotide substitutions per site.
3.3. Microplastic Biodegradation
The strains AQ3A, MQ1B, and AQ2A showed stronger growth in the presence of LDPEMPs (Table 3). After 28 days of treatment, the final biomass values for AQ3A, MQ1B, and AQ2A were 0.0890 g·mL−1, 0.0695 g·mL−1, and 0.0575 g·mL−1, respectively. In contrast, the MQ1A, MQ1C, and MQ2A strains showed a decrease in biomass between the 14th and 21st day of the assay. The residual weight of LDPEMPs was dependent on both time and fungal strain. The strains AQ3A, MQ1C, and MQ1B demonstrated the highest degradation rates, at 47%, 41%, and 38%, respectively. The control without inoculum showed a weight loss reduction of up to 0.005 g. Based on biomass formation and LDPEMPs reduction, the strain AQ3A, identified as Aspergillus sp., was considered the most promising.
Table 3.
Biodegradation of microplastics (MPs) exposed to mangrove-isolated fungal strains.
3.4. FTIR Analysis
According to the FTIR spectra obtained, it was possible to observe structural changes from the 21st day of incubation of LDPEMPs in the presence of the AQ3A fungus (Figure 4). These peaks were detected in the regions of 1000–1250 cm−1, 1750–1500 cm−1, and 3500–3250 cm−1 and indicate the addition of hydroxide groups and folding changes in the side chains. The change in intensity and formation of these new peaks at different wavelengths indicate that LDPEMPs became more hydrophilic. The control samples did not present structural changes throughout the test period.
Figure 4.
Fourier-transform infrared spectroscopy (FTIR) analysis of low-density polyethylene microplastics (LDPEMPs), before and after biodegradation test, using AQ3A strain. (A) Treatment after seven days, (B) treatment after 14 days, (C) treatment after 21 days, (D) treatment after 28 days, (E) control containing only LDPEMPs after 7 days, and (F) control containing only LDPEMPs after 28 days.
3.5. Laccase Activity
Although the laccase (Lcc) enzyme assists in the oxidation of hydrocarbon structures, its activity in the supernatant was not detected. The absorbance variations observed by the ABTS (2,2′-azino-bis(3-ethylbenzothiazoline-6-sulfonic acid)) method for enzymatic testing of Lcc was considered non-existent. However, given the observed weight reduction of LDPEMPs, it is necessary to evaluate underlying mechanisms and other oxidoreductase enzymes for their potential contribution to the biodegradation process, particularly due to the ability to make LDPEMPs hydrophilic.
4. Discussion
4.1. Low-Density Polyethylene Microplastics and Marine Aquatic Pollution
Approximately one-third of global plastic production involves polyethylene (PE). Among the main types of PE available on the market, LDPE is considered one of the most important due to its low cost and wide applicability, especially in the food packaging and agricultural sectors [43]. According to the literature, the presence of LDPE in aquatic environments has been found both in the water column and in sediments. Under continuous exposure to biotic and abiotic factors, these polymers fragment into smaller particles, either MPs or nanoplastics (NPs) [44]. These can be classified into different morphological categories, including fragments, fibers, films, foam, and beads [45].
Turra et al. [46] and Izar et al. [47] reported the presence of 13,138 microbeads/m3 in coastal regions of São Paulo State and 29,775.75 microbeads/m3 in Santos Bay. Crew et al. [48] observed that 95% of the MPs found in benthic sediment in the Saint Lawrence River, Canada, were composed of microbeads smaller than 400 μm. Scherer et al. [49] detected a rate of 20% microbeads in the water column and 35.5% in sediments of the Elbe River, Germany. Regarding PEMPs, Renzi et al. [50] conducted studies on Salinan Island, Italy, and detected 20% PE in the sediment. This same percentage of PE was detected by Abassi et al. [51] in Fars, Iran, with MP sizes ranging from 1 to 100 μm. Sarkar et al. [52] analyzed sediments from the banks of the Ganges River, India, and found that approximately 30% of the MPs analyzed were identified as PE.
These findings underscore the pervasive presence and persistence of LDPEMPs in various aquatic environments worldwide. The significant concentrations of MPs, particularly in coastal and river sediments, highlight the urgent need for comprehensive strategies to mitigate plastic pollution. Future research should focus on the long-term ecological impacts of these pollutants and the development of effective biodegradation methods to address this growing environmental challenge.
4.2. Fungal Isolates Identification
The isolation of Ff has been primarily focused on their biotechnological applications, especially those isolated from marine ecosystems, which have unique physiological properties distinct from terrestrial fungi. Ameen et al. [53] isolated 45 Ff from mangrove sediments to test their potential to biodegrade LDPE in a medium containing 20 g·L−1 of glucose as a carbon source. The study highlighted that the genera Aspergillus, Penicillium, and Candida were the most representative. Saénz et al. [54] isolated strains exclusively from the Aspergillus genus, from Ecuadorian mangroves and saline intertidal zones. The isolated species Aspergillus niger and A. terreus demonstrated the ability to biodegrade LDPE. Sangale et al. [55] isolated 109 Ff from Indian mangroves, but only A. awamori, A. niger, A. terreus, A. sydowii, Meyerozima guillermondii, and Penicillium chrysogenum showed the ability to biodegrade PE. Devi et al. [56] isolated Aspergillus tubingensis VRKPT1 and Aspergillus flavus VRKPT2 from plastic waste in the coastal area of the Gulf of Mannar, India. According to the authors, A. tubingensis and A. flavus promoted a reduction in high-density polyethylene (HDPE) film by 6.02 ± 0.2% and 8.51 ± 0.1%, respectively.
In recent years, there has been a significant increase in studies related to the biodegradation of microplastics using fungi (Table 4).
Table 4.
Recent advances in microplastic (MP) degradation using filamentous fungi (Ff).
4.3. Microplastic Mycodegradation
Ojha et al. [62] evaluated the species Penicillium oxalicum and P. chrysogenum for their ability to biodegrade LDPEMPs over 90 days. The LDPEMPs samples showed reductions of 36.6% and 34.55% for P. oxalicum and P. chrysogenum, respectively. The biomass formed by P. oxalicum was 0.034 g·L−1, while that for P. chrysogenum was 0.043 g·L−1. Munir et al. [63] identified that the fungus Trichoderma viride, isolated from a landfill, reduced the LDPEMPs by 5.13% after 45 days of incubation. Hikmah et al. [64] found that up to 7.51% of LDPEMPs were reduced in the presence of different strains of Trichoderma over a period of 35 days. The authors described a slow and reduced rate of biomass formation, similar to our study with MQ2A, which showed the lowest biomass formation. In the present study, the biodegradation rates obtained for the Trichoderma aff. pseudokoningii strains MQ2A and MQ1B were 17% and 38%, respectively.
Muhonja et al. [65] analyzed 20 different Ffs over 112 days. Aspergillus oryzae and A. fumigatus were the microorganisms that presented the highest rates of LDPEMPs biodegradation, at 36.4% and 24.1%, respectively. Taghavi et al. [66] verified the action of A. flavus on HDPEMPs over 100 days, obtaining a 5.5% weight loss of MPs. El-Sayed et al. [67] achieved 39.1% biodegradation in a consortium of A. carbonarius and A. fumigatus over 112 days of incubation. In short, the biodegradation rates observed in different studies are comparable to those in this study, except for Trichoderma strains. However, despite the similarity in values, the morphological differences of PEMPs used should be considered. While most studies use microfilms as the target polymer, this study aimed to use PE microspheres, which can provide a larger surface area for fungal mycelium interaction with the polymeric material. Additionally, the varying conditions of the culture medium and concentration of MPs in each evaluation must be considered, as they directly influence the biodegradation capacity of each strain.
4.4. Polymeric Chains Disruption
Plastic biodegradation processes can be assessed through changes in crystallinity, molecular weight, tensile properties, extent of fragmentation, and functional groups found on the plastic surface [19]. Černoša et al. [68] selected potential plastic-degrading fungi. According to the authors, results obtained by attenuated total reflectance (ATR)-FTIR spectra of LDPE exposed to the fungus Rhodotorula sp. EXF-10630 showed characteristic bands corresponding to -CH2- stretching (st, 2915 and 2840 cm−1), in-plane bending (bd-ip, 1463 and 1377 cm−1 319), and C-H rocking (rk, 718 cm−1 320).
The reduction of LDPE hydrophobicity indicates that the fungal strain secreted enzymes and polysaccharides, specifically exopolysaccharides, which aid in strong adhesion to the plastic surface [18]. According to Kirstein et al. [69], exopolysaccharides act as surfactants, favoring the reduction of hydrophobicity and consequent penetration rate of species of microorganisms in the plastic polymer [18,69]. Hydrophilicity also allows different oxidoreductase enzymes to catalyze hydrolytic cleavage, depolymerizing the molecular structure of LDPE, which favors the assimilation process [70]. The potential occurrence of chain scission and oxidation reactions was observed in the FTIR spectra obtained in a study conducted by Ferreira-Filipe et al. [57] when they exposed complex mixtures of electronic waste polymers (EWP) to the fungus Penicillium brevicompactum for a period of 28 days. According to the authors, the peaks obtained at 1449 cm−1 and 1385 cm−1 can be attributed to the C-H deformation of CH2 and CH3 and to the CH3 deformation of C-(CH3). This set of evidence strongly suggests the ability of the fungus to biodegrade EWP, inducing changes in functional groups and increasing physical deterioration.
4.5. Enzymatic Activities Associated with Microplastic Degradation
Kang et al. [71] inferred that the yield of Lcc may increase depending on the presence of inducing substances in fungal cultures during the biodegradation process. Likewise, studies reveal that the production of Lcc during the biodegradation process of PEMPs occurs when glucose becomes a limiting factor [72]. However, considering that in our study, the presence of Lcc was not detected in the reduction process of the polymeric material, underlying mechanisms and other oxidoreductase enzymes need to be evaluated for their possible contribution to the involvement of the biodegradation process or the increase in the hydrophilicity of the material [73]. Microbial enzymes such as manganese peroxidase and lipase, for example, are capable of degrading PEMPs by activating their hydrolytic cleavage [73]. Kang et al. [71] also suggest that lipase production may be higher when compared to Lcc and manganese peroxidase.
5. Conclusions
This study highlights the potential of mangrove-isolated fungi in degrading LDPEMPs. The most effective reduction of LDPEMPs was achieved with three isolates of Aspergillus sp. (AQ3A, MQ1C, and AQ2A). However, these isolates could not be identified at the species level due to the limited resolution of the Aspergillus clade in the phylogenetic analysis.
Among all isolates, Aspergillus sp. AQ3A showed the most promising results, with a 47% reduction of LDPEMPs and biomass formation of 0.0890 g·mL⁻1. The other two Aspergillus strains, MQ1C and MQ1B, also demonstrated significant reductions of 41% and 38%, respectively, with corresponding biomass formations of 0.0415 and 0.0695 g·mL⁻1. Despite the inability to identify the strains at the species level, complementary studies using FTIR with Aspergillus sp. AQ3A highlighted changes in the molecular structure of LDPEMPs. Furthermore, the absence of Lcc activity in the extracellular extract suggests that other enzymatic mechanisms are at play.
These results suggest a viable solution to the environmental threat posed by LDPEMPs, with the possibility of implementing bioremediation actions using Ff with a particular focus on Aspergillus species. Future studies will focus on identifying these isolates at the species level and further investigating their action on LDPEMPs and other potential pollutants. Additionally, further exploration of the enzymes involved in this process is necessary to fully understand and optimize their biodegradation capabilities.
Author Contributions
Conceptualization, A.A., C.O., L.d.C., M.F.S., R.P. and Y.D.; validation, A.A., C.O., L.C., L.G., M.F., M.F.S., N.F., R.P. and Y.D.; formal analysis, A.A., A.N., C.O., L.d.C., L.G., M.F., M.F.S., R.d.S., R.P. and Y.D.; investigation, A.A., A.N., C.O., L.C., L.G., M.F., M.F.S., N.F., S.K., R.d.S. and Y.D.; resources, C.O., L.d.C. and R.P.; writing—original draft preparation, A.A., A.N., C.O., L.C., L.d.C., L.G., M.F., N.F., S.K., R.P. and Y.D.; writing—review and editing, A.A., A.N., C.O., L.d.C., L.G., M.F., M.F.S., R.d.S., N.F., S.K., R.P. and Y.D.; supervision, A.N., C.O., L.d.C., M.F., R.d.S., R.P. and Y.D.; project administration, A.N., C.O., L.d.C., R.P., R.d.S. and Y.D; funding acquisition, C.O., L.d.C. and R.P. All authors have read and agreed to the published version of the manuscript.
Funding
The research described in this work was supported by the São Paulo Research Foundation (FAPESP; grant #2020/12867-2; #2019/16023-6), Conselho Nacional de Desenvolvimento Científico e Tecnológico (CNPq, grant # 421122/2023-4; #404912/2021-4), Minas Gerais Research Foundation (FAPEMIG; grant # APQ-00085-21; #BPD-00030-22). Marta Filipa Simões acknowledges Science and Technology Development Fund (FDCT), Macau SAR, File no. file no. 0002-2024-SKL. Arthur Pérez Aguiar acknowledges scholarships financial support from and Coordination for the Improvement of Higher Education Personnel (CAPES; grant #8887.674369/2022-00). Leticia Fontes Gama acknowledges the financial support from FAPESP scholarships (grant #2021/11074-1) and CNPq (grant#131422/2024-3).
Institutional Review Board Statement
Not applicable.
Informed Consent Statement
Not applicable.
Data Availability Statement
Sequences analised are available on Genbank through the accession numbers listed in Table 1.
Acknowledgments
The authors would also like to extend their gratitude to Sara Silvério, from Minho University (Portugal), for her help in completing this research.
Conflicts of Interest
The authors declare no conflicts of interest. The funders had no role in the design of the study; in the collection, analyses, or interpretation of data; in the writing of the manuscript, or in the decision to publish the results.
References
- Garcés-Ordóñez, O.; Saldarriaga-Vélez, J.F.; Espinosa-Díaz, L.F.; Patiño, A.D.; Cusba, J.; Canals, M.; Mejía-Esquivia, K.; Fragozo-Velásquez, L.; Sáenz-Arias, S.; Córdoba-Meza, T.; et al. Microplastic pollution in water, sediments and commercial fish species from Ciénaga Grande de Santa Marta lagoon complex, Colombian Caribbean. Sci. Total Environ. 2022, 829, 154643. [Google Scholar] [CrossRef] [PubMed]
- Liu, L.; Xu, M.; Ye, Y.; Zhang, B. On the degradation of (micro)plastics: Degradation methods, influencing factors, environmental impacts. Sci. Total Environ. 2022, 806, 151312. [Google Scholar] [CrossRef] [PubMed]
- Khan, N.A.; Khan, A.H.; López-Maldonado, E.A.; Alam, S.S.; López, J.R.L.; Herrera, P.F.M.; Mohamed, B.A.; Mahmoud, A.E.D.; Abutaleb, A.; Singh, L. Microplastics: Occurrences, treatment methods, regulations and foreseen environmental impacts. Environ. Res. 2022, 215, 114224. [Google Scholar] [CrossRef] [PubMed]
- Zhang, J.; Ren, S.; Xu, W.; Liang, C.; Li, J.; Zhang, H.; Li, Y.; Liu, X.; Jones, D.L.; Chadwick, D.R.; et al. Effects of plastic residues and microplastics on soil ecosystems: A global meta-analysis. J. Hazard. Mater. 2022, 435, 129065. [Google Scholar] [CrossRef]
- Madhumitha, C.T.; Karmegam, N.; Biruntha, M.; Arun, A.; Al Kheraif, A.A.; Kim, W.; Kumar, P. Extraction, identification, and environmental risk assessment of microplastics in commercial toothpaste. Chemosphere 2022, 296, 133976. [Google Scholar] [CrossRef] [PubMed]
- Mateos-Cárdenas, A.; Moroney, A.G.; Pelt, F.N.A.M.; O’Halloran, J.; Jansen, M.A.K. Trophic transfer of microplastics in a model freshwater microcosm; lack of a consumer avoidance response. Food Webs 2022, 31, e00228. [Google Scholar] [CrossRef]
- Rakib, M.R.J.; Sarker, A.; Ram, K.; Uddin, M.G.; Walker, T.R.; Chowdhury, T.; Uddin, J.; Khandaker, M.U.; Rahman, M.M.; Idris, A.M. Microplastic toxicity in aquatic organisms and aquatic ecosystems: A Review. Water Air Soil. Pollut. 2023, 234, 52. [Google Scholar] [CrossRef]
- Ziajahromi, S.; Kumar, A.; Neale, P.A.; Leusch, F.D.L. Environmentally relevant concentrations of polyethylene microplastics negatively impact the survival, growth and emergence of sediment-dwelling invertebrates. Environ. Pollut. 2018, 236, 425–431. [Google Scholar] [CrossRef]
- Détrée, C.; Gallardo-Escárate, C. Single and repetitive microplastics exposures induce immune system modulation and homeostasis alteration in the edible mussel Mytilus galloprovincialis. Fish Shellfish Immunol. 2018, 83, 52–60. [Google Scholar] [CrossRef]
- Solomando, A.; Capó, X.; Alomar, C.; Compa, M.; Valencia, J.M.; Sureda, A.; Deudero, S. Assessment of the effect of long-term exposure to microplastics and depuration period in Sparus aurata Linnaeus, 1758: Liver and blood biomarkers. Sci. Total Environ. 2021, 786, 147479. [Google Scholar] [CrossRef]
- Schirinzi, G.F.; Pérez-Pomeda, I.; Sanchís, J.; Rossini, C.; Farré, M.; Barceló, D. Cytotoxic effects of commonly used nanomaterials and microplastics on cerebral and epithelial human cells. Environ. Res. 2017, 159, 579–587. [Google Scholar] [CrossRef] [PubMed]
- Bacha, A.U.R.; Nabi, I.; Zaheer, M.; Jin, W.; Yang, L. Biodegradation of macro- and micro-plastics in environment: A review on mechanism, toxicity, and future perspectives. Sci. Total Environ. 2023, 858, 160108. [Google Scholar] [CrossRef] [PubMed]
- Shirazi, S.; Mafigholami, R.; Moghimi, H.; Borghei, S.M. Feasibility study of microplastic biodegradation in effluents from South Tehran WWTP after quantitative and qualitative measurement of the particles. Appl. Water Sci. 2023, 13, 80. [Google Scholar] [CrossRef]
- Miri, S.; Saini, R.; Davoodi, S.M.; Pulicharla, R.; Brar, S.K.; Magdouli, S. Biodegradation of microplastics: Better late than never. Chemosphere 2022, 286, 131670. [Google Scholar] [CrossRef] [PubMed]
- Thakur, B.; Singh, J.; Singh, J.; Angmo, D.; Vig, A.P. Biodegradation of different types of microplastics: Molecular mechanism and degradation efficiency. Sci. Total Environ. 2023, 877, 162912. [Google Scholar] [CrossRef]
- Srikanth, M.; Sandeep, T.S.R.S.; Sucharitha, K.; Godi, S. Biodegradation of plastic polymers by fungi: A brief review. Bioresour. Bioprocess. 2022, 9, 42. [Google Scholar] [CrossRef]
- Li, S.; Yang, Y.; Yang, S.; Zheng, H.; Zheng, Y.; Jun, M.; Nagarajan, D.; Varjani, S.; Chang, J.S. Recent advances in biodegradation of emerging contaminants-microplastics (MPs): Feasibility, mechanism, and future prospects. Chemosphere 2023, 331, 138776. [Google Scholar] [CrossRef]
- Kumar, K.; Sharma, N.; Duhan, L.; Pasrija, R.; Thomas, J.; Umesh, M.; Lakkaboyana, S.K.; Andler, R.; Vangnai, A.S.; Vithanage, M.; et al. Microbial engineering strategies for synthetic microplastics clean up: A review on recent approaches. Environ. Toxicol. Pharm. 2023, 98, 104045. [Google Scholar] [CrossRef]
- Sánchez, C. Fungal potential for the degradation of petroleum-based polymers: An overview of macro- and microplastics biodegradation. Biotechnol. Adv. 2020, 40, 107. [Google Scholar] [CrossRef]
- Niu, L.; Wang, Y.; Li, Y.; Lin, L.; Chen, Y.; Shen, J. Occurrence, Degradation pathways, and potential synergistic degradation mechanism of microplastics in surface water: A Review. Curr. Pollution Rep. 2023, 9, 312–326. [Google Scholar] [CrossRef]
- Zhang, J.; Gao, D.; Li, Q.; Zhao, Y.; Li, L.; Lin, H.; Bi, Q.; Zhao, Y. Biodegradation of polyethylene microplastic particles by the fungus Aspergillus flavus from the guts of wax moth Galleria mellonella. Sci. Total Environ. 2020, 704, 135931. [Google Scholar] [CrossRef] [PubMed]
- Paço, A.; Duarte, K.; Costa, J.P.; Santos, P.S.M.; Pereira, R.; Pereira, M.E.; Freitas, A.C.; Duarte, A.C.; Rocha-Santos, T.A.P. Biodegradation of polyethylene microplastics by the marine fungus Zalerion maritimum. Sci. Total Environ. 2017, 586, 10–15. [Google Scholar] [CrossRef]
- Temporiti, M.E.E.; Nicola, L.; Nielsen, E.; Tosi, S. Fungal enzymes involved in plastics biodegradation. Microorganisms 2022, 10, 1180. [Google Scholar] [CrossRef]
- Simões, M.F.; Antunes, A.; Ottoni, C.A.; Amini, M.S.; Alam, I.; Alzubaidy, H.; Mokhtar, N.A.; Archer, J.A.; Bajic, V.B. Soil and rhizosphere associated fungi in gray mangroves (Avicennia marina) from the Red Sea—A metagenomic approach. Genom. Proteom. Bioinform. 2015, 13, 310–320. [Google Scholar] [CrossRef] [PubMed]
- Hidalgo-Ruz, V.; Gutow, L.; Thompson, R.C.; Thiel, M. Microplastics in the marine environment: A review of the methods used for identification and quantification. Environ. Sci. Technol. 2021, 46, 3060–3075. [Google Scholar] [CrossRef]
- Yang, S.; Xu, W.; Zhang, K.; Hu, J.; Gao, Y.; Cui, G.; Grossart, H.-P.; Luo, Z. Fungal communities differ with microplastic types in deep sea sediment enrichments of the Eastern Pacific. Int. Biodeterior. Biodegrad. 2022, 173, 105461. [Google Scholar] [CrossRef]
- Mathur, G.; Prasad, R. Degradation of polyurethane by Aspergillus flavus (ITCC 6051) isolated from soil. Appl. Biochem. Biotechnol. 2012, 167, 1595–1602. [Google Scholar] [CrossRef]
- Simões, M.F.; Pereira, L.; Santos, C.; Lima, N. Polyphasic identification and preservation of fungal diversity: Concepts and applications. In Management of Microbial Resources in the Environment; Springer: Dordrecht, The Netherlands, 2013; pp. 91–117. [Google Scholar]
- Saif, F.A.; Yaseen, S.A.; Alameen, A.S.; Mane, S.B.; Undre, P.B. Identification and characterization of Aspergillus species of fruit rot fungi using microscopy, FT-IR, Raman and UV–Vis spectroscopy. Spectrochim. Acta A Mol. Biomol. Spectrosc. 2021, 246, 2021. [Google Scholar] [CrossRef]
- White, T.J.; Bruns, T.; Lee, S.; Taylor, J. Amplification and direct sequencing of fungal ribosomal RNA genes for phylogenetics. In PCR Protocols: A Guide to Methods and Applications; Innis, M., Gelfand, D., Sninsky, J., White, T., Eds.; Academic Press: San Diego, CA, USA, 1990; pp. 315–322. [Google Scholar]
- Gardes, M.; Bruns, T.D. ITS primers with enhanced specificity for basidiomycetes—Application to the identification of mycorrhizae and rusts. Mol. Ecol. 1993, 2, 113–118. [Google Scholar] [CrossRef]
- Hall, T.A. BioEdit: A user-friendly biological sequence alignment editor and analysis program for Windows 95/98/NT. Nucleic Acids Symp. Ser. 1999, 41, 95–98. [Google Scholar]
- Benson, D.A.; Cavanaugh, M.; Clark, K.; Karsch-Mizrachi, I.; Ostell, J.; Pruitt, K.D.; Sayers, E.W. Genbank. Nucleic Acids Res. 2018, 46, D41–D47. [Google Scholar] [CrossRef] [PubMed]
- Altschul, S.F.; Gish, W.; Miller, W.; Myers, E.W.; Lipman, D.J. Basic local alignment search tool. J. Mol. Biol. 1990, 215, 403–410. [Google Scholar] [CrossRef] [PubMed]
- Thompson, J.D.; Higgins, D.G.; Gibson, T.J. ClustalW: Improving the sensivity of progressive multiple sequence alignment through sequence weighting, position specific gap penalties and weight matrix choice. Nucleic Acids Res. 1994, 22, 4673–4680. [Google Scholar] [CrossRef] [PubMed]
- Posada, D.; Crandall, K.A. MODELTEST: Testing the model of DNA substitution. Bioinformatics 1998, 14, 817–818. [Google Scholar] [CrossRef] [PubMed]
- Ronquist, F.; Teslenko, M.; van der Mark, P.; Ayres, D.L.; Darling, A.; Höhna, S.; Larget, B.; Liu, L.; Suchard, M.A.; Huelsenbeck, J.P. Efficient Bayesian phylogenetic inference and model selection across a large model space. Syst. Biol. 2012, 61, 539–542. [Google Scholar] [CrossRef]
- Altekar, G.; Dwarkadas, S.; Huelsenbeck, J.P.; Ronquist, F. Parallel Metropolis coupled Markov chain Monte Carlo for Bayesian phylogenetic inference. Bioinformatics 2004, 20, 407–415. [Google Scholar] [CrossRef]
- Rambaut, A. FigTree, v 1.4.4. 2018. Available online: http://tree.bio.ed.ac.uk/software/figtree/ (accessed on 10 September 2024).
- Wang, D.; Su, L.; Ruan, H.D.; Chen, J.; Lu, J.; Lee, C.H.; Jiang, S.Y. Quantitative and qualitative determination of microplastics in oyster, seawater and sediment from the coastal areas in Zhuhai, China. Mar. Pollut. Bull. 2021, 164, 112000. [Google Scholar] [CrossRef]
- Duan, J.; Han, J.; Zhou, H.; Lau, Y.L.; An, W.; Wei, P.; Cheung, S.G.; Yang, Y.; Tam, N.F. Development of a digestion method for determining microplastic pollution in vegetal-rich clayey mangrove sediments. Sci. Total Environ. 2020, 707, 136030. [Google Scholar] [CrossRef]
- Silvério, S.C.; Rodríguez, O.; Tavares, A.P.M.; Teixeira, J.A.; Macedo, E.A. Laccase recovery with aqueous two-phase systems: Enzyme partitioning and stability. J. Mol. Catal. B Enzym. 2013, 87, 37–43. [Google Scholar] [CrossRef]
- Ali, N.; Khan, M.H.; Ali, M.; Sidra; Ahmad, S.; Khan, A.; Nabi, G.; Ali, F.; Bououdina, M.; Kyzas, G.Z. Insight into microplastics in the aquatic ecosystem: Properties, sources, threats and mitigation strategies. Sci. Total Environ. 2024, 913, 169489. [Google Scholar] [CrossRef]
- Chen, Y.Y.; Cheng, X.T.; Zeng, Y.Q. The occurrence of microplastic in aquatic environment and toxic effects for organisms. Int. J. Environ. Sci. Technol. 2023, 20, 10477–10490. [Google Scholar] [CrossRef]
- Khedre, A.M.; Ramadan, S.A.; Ashry, A.; Alaraby, M. Abundance and risk assessment of microplastics in water, sediment, and aquatic insects of the Nile River. Chemosphere 2024, 353, 141557. [Google Scholar] [CrossRef] [PubMed]
- Turra, A.; Manzano, A.B.; Dias, R.J.S.; Mahiques, M.M.; Barbosa, L.; Balthazar-Silva, D.; Moreira, F.T. Three-dimensional distribution of plastic pellets in sandy beaches: Shifting paradigms. Sci. Rep. 2014, 4, 4435. [Google Scholar] [CrossRef] [PubMed]
- Izar, G.M.; Morais, L.G.; Pereira, C.D.S.; Cesar, A.; Abessa, D.M.S.; Christofoletti, R.A. Quantitative analysis of pellets on beaches of the São Paulo coast and associated non-ingested ecotoxicological effects on marine organisms. Reg. Stud. Mar. Sci. 2019, 29, 100705. [Google Scholar] [CrossRef]
- Crew, A.; Gregory-Eavez, I.; Riciiardi, A. Distribution, abundance, and diversity of microplastics in the upper St. Lawrence River. Environ. Pollut. 2020, 260, 113994. [Google Scholar] [CrossRef]
- Scherer, C.; Weber, A.; Stock, F.; Vurusic, S.; Egerci, H.; Kochleus, C.; Reifferscheid, G. Comparative assessment of microplastics in water and sediment of a large European river. Sci. Total Environ. 2020, 738, 139866. [Google Scholar] [CrossRef]
- Renzi, M.; Blašković, A.; Broccoli, A.; Bernardi, G.; Grazioli, E.; Russo, G. Chemical composition of microplastic in sediments and protected detritivores from different marine habitats (Salina Island). Mar. Pollut. Bull. 2020, 152, 110918. [Google Scholar] [CrossRef]
- Abbasi, S.; Turner, A. Dry and wet deposition of microplastics in a semi-arid region (Shiraz, Iran). Sci. Total Environ. 2020, 786, 147358. [Google Scholar] [CrossRef]
- Sarkar, D.J.; Sarkar, S.D.; Das, B.K.; Manna, R.K.; Behera, B.K.; Samanta, S. Spatial distribution of meso and microplastics in the sediments of river Ganga at eastern India. Sci. Total Environ. 2019, 1, 133717. [Google Scholar] [CrossRef]
- Ameen, F.; Moslem, M.; Hadi, S.; Al-Sabri, A.E. Biodegradation of low density polyethylene (LDPE) by mangrove fungi from the Red Sea Coast. Prog. Rubber Plast. Recycl. Technol. 2015, 31, 125–144. [Google Scholar] [CrossRef]
- Saénz, M.; Borodulina, T.; Diaz, L.; Banchon, C. Minimal conditions to degrade low density polyethylene by Aspergillus terreus and niger. J. Ecol. Eng. 2019, 20, 44–51. [Google Scholar] [CrossRef] [PubMed]
- Sangale, M.K.; Shahnawaz, M.; Ade, A.B. Potential of fungi isolated from the dumping sites mangrove rhizosphere soil to degrade polythene. Sci. Rep. 2019, 9, 5390. [Google Scholar] [CrossRef] [PubMed]
- Devi, R.S.; Kannan, V.R.; Nivas, D.; Kannan, K.; Chandru, S.; Antony, A.R. Biodegradation of HDPE by Aspergillus spp. from marine ecosystem of Gulf of Mannar, India. Mar. Pollut. Bull. 2015, 96, 32–40. [Google Scholar] [CrossRef]
- Ferreira-Filipe, D.A.; Oliveira, L.; Paço, A.; Fernandes, A.J.S.; Costa, F.M.; Duarte, A.C.; Rocha-Santos, T.; Silva, A.L.P. Biodegradation of e-waste microplastics by Penicillium brevicompactum. Sci. Total Environ. 2024, 935, 173334. [Google Scholar] [CrossRef] [PubMed]
- Sathiyabama, M.; Boomija, R.V.; Sathiyamoorthy, T.; Mathivanan, N.; Balaji, R. Mycodegradation of low-density polyethylene by Cladosporium sphaerospermum, isolated from platisphere. Sci. Rep. 2024, 14, 8351. [Google Scholar] [CrossRef]
- Duan, Y.; Yin, Y.; Ni, Z.; Liu, J.; Gui, H.; Wu, D.; Wu, X.; Wang, L. The effective and green biodegradation of polyethylene microplastics by the screening of a strain with its degrading enzymes. Biochem. Eng. J. 2024, 210, 109429. [Google Scholar] [CrossRef]
- Khan, S.; Ali, S.A.; Ali, A.S. Biodegradation of low density polyethylene (LDPE) by mesophilic fungus ‘Penicillium citrinum’ isolated from soils of plastic waste dump yard, Bhopal, India. Environ. Technol. 2022, 44, 2300–2314. [Google Scholar] [CrossRef]
- Wu, F.; Guo, Z.; Cui, K.; Dong, D.; Yang, X.; Li, J.; Wu, Z.; Li, L.; Dai, Y.; Pan, T. Insights into characteristics of white rot fungus during environmental plastics adhesion and degradation mechanism of plastics. J. Hazard Mater 2023, 448, 130878. [Google Scholar] [CrossRef] [PubMed]
- Ojha, N.; Pradhan, N.; Singh, S.; Barla, A.; Shrivastava, A.; Khatya, P.; Rai, V.; Bose, S. Evaluation of HDPE and LDPE degradation by fungus, implemented by statistical optimization. Sci. Rep. 2018, 7, 39515. [Google Scholar] [CrossRef]
- Munir, E.; Harefa, R.S.M.; Priyani, N.; Suryanto, D. Plastic degrading fungi Trichoderma viride and Aspergillus nomius isolated from local landfill soil in Medan. IOP Conf. Ser. Earth Environ. Sci. 2018, 126, 012145. [Google Scholar] [CrossRef]
- Hikmah, M.; Setyaningsih, R.; Pangastuti, A. The potential of lignolytic Trichoderma isolates in LDPE (low density polyethylene) plastic biodegradation. IOP Conf. Ser. Mater. Sci. Eng. 2018, 333, 012076. [Google Scholar] [CrossRef]
- Muhonja, C.N.; Makonde, H.; Magoma, G.; Imbuga, M. Biodegradability of polyethylene by bacteria and fungi from Dandora dumpsite Nairobi-Kenya. PLoS ONE 2018, 13, e0198446. [Google Scholar] [CrossRef] [PubMed]
- Taghavi, N.; Singhal, N.; Zhuang, W.Q.; Baroutian, S. Degradation of plastic waste using stimulated and naturally occurring microbial strains. Chemosphere 2021, 263, 127975. [Google Scholar] [CrossRef] [PubMed]
- El-Sayed, M.T.; Rabie, G.H.; Hamed, E.A. Biodegradation of low-density polyethylene (LDPE) using the mixed culture of Aspergillus carbonarius and A. fumigates. Environ. Dev. Sustain. 2021, 23, 14556–14584. [Google Scholar] [CrossRef]
- Černoša, A.; Cortizas, A.M.; Traoré, M.; Podlogar, M.; Danevčič, T.; Gunde-Cimerman, N.; Gostinčar, C. A screening method for plastic-degrading fungi. Heliyon 2024, 10, e31130. [Google Scholar] [CrossRef]
- Kirstein, I.V.; Wichels, A.; Gullans, E.; Krohne, G.; Gerdts, G. The plastisphere—Uncovering tightly attached plastic “specific” microorganisms. PLoS ONE 2019, 14, e0215859. [Google Scholar] [CrossRef]
- Pathak, V.M. Navneet Review on the current status of polymer degradation: A microbial approach. Bioresour. Bioprocess. 2017, 4, 15. [Google Scholar] [CrossRef]
- Kang, B.R.; Kim, S.B.; Song, H.A.; Lee, T.K. Accelerating the biodegradation of high-density polyethylene (HDPE) using Bjerkandera adusta TBB-03 and lignocellulose substrates. Microorganisms 2019, 7, 304. [Google Scholar] [CrossRef]
- Gómez-Méndez, L.D.; Moreno-Bayona, D.A.; Poutou-Piñales, R.A.; Salcedo-Reyes, J.C.; Pedroza-Rodríguez, A.M.; Vargas, A.; Bogoya, J.M. Biodeterioration of plasma pretreated LDPE sheets by Pleurotus ostreatus. PLoS ONE 2018, 13, e0203786. [Google Scholar] [CrossRef]
- Restrepo-Flórez, J.M.; Bassi, A.; Thompson, M.R. Microbial degradation and deterioration of polyethylene—A review. Int. Biodeterior. Biodegrad. 2015, 88, 83–90. [Google Scholar] [CrossRef]
Disclaimer/Publisher’s Note: The statements, opinions and data contained in all publications are solely those of the individual author(s) and contributor(s) and not of MDPI and/or the editor(s). MDPI and/or the editor(s) disclaim responsibility for any injury to people or property resulting from any ideas, methods, instructions or products referred to in the content. |
© 2024 by the authors. Licensee MDPI, Basel, Switzerland. This article is an open access article distributed under the terms and conditions of the Creative Commons Attribution (CC BY) license (https://creativecommons.org/licenses/by/4.0/).